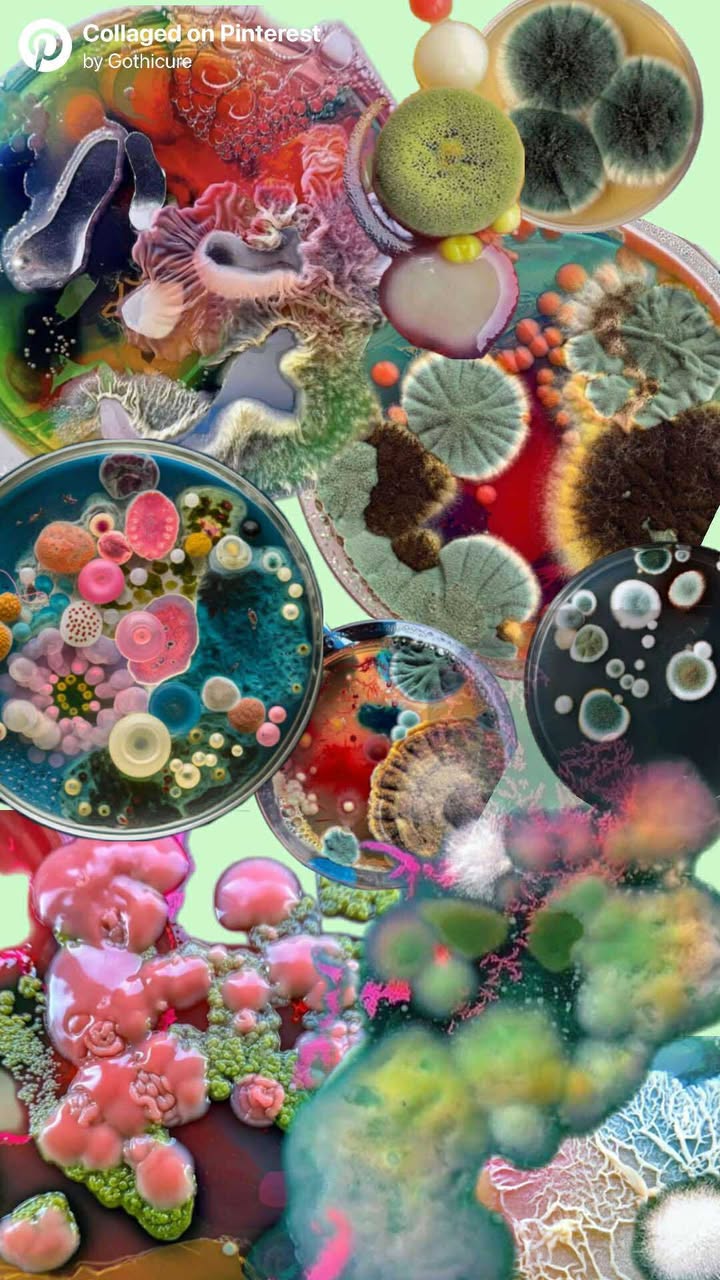

Products
-
"Fairest of them all" XXL square press on set // Size L -
"I love me" short almond press-on set. -
"Safari chic" medium almond press-on nails // Size M -
"Sugar and spice" medium stiletto press-on nails // Size: XS -
"Sweater weather" long coffin press-on nails //Size M -
"Till death and beyond" medium almond press on set // Size M -
"Twisted cheer" medium almond press on set // Size M -
Amy Winehouse short almond press-on set -
Beetlejuice inspired press-on set // size: M -
Butterfly wing inspired medium square press-on set. -
Ego trip -
Ghost face medium almond press-on set // Size: M -
Gothicure gift card -
Hey nostalgia! 90s cartoon inspired set -
Holy Vice -
Island alien cartoon character inspired medium coffin press on set. -
Lana Del Rey medium coffin press-on set. -
Nostalgic 90s cartoon inspired press on nails in medium square. -
Petri dish -
Sabrina Carpenter long coffin press-on nails // Size: S -
Sailormoon inspired short coffin press-on set. -
“Creepmas cheer” SIZE S // Medium length almond press-on nails -
“Holiday wrap” short coffin press on set // SIZE M -
“The winter classic” SIZE M // Medium length square press-on set